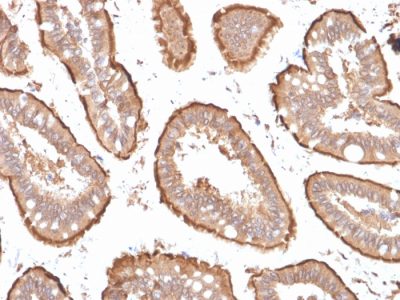

Villin Monoclonal Mouse Antibody (VIL1/1314 + VIL1/2376)
CONJUGATION
产品详情
产品属性
常见问题
识别 95 kDa 的蛋白质,该蛋白质被鉴定为绒毛蛋白。它是微绒毛中的主要成分,构成上皮细胞的刷状缘,形成肠和肾近端肾小管上皮的吸收表面。Anti-Villin 标记胃肠道黏膜上皮和泌尿生殖道的刷状缘区域。在肿瘤中,绒毛蛋白主要在结直肠起源的肿瘤中表达。绒毛蛋白抗体可用于鉴定原发性和转移性结直肠癌的恶性细胞。该抗体还标记皮肤的默克尔细胞。
一抗可提供纯化的,或带有荧光 CF® 染料和其他标记的选择。CF® 染料具有出色的亮度和光稳定性。有关更多信息,请参阅CF® 染料手册。注意:不推荐使用 CF®405S 和 CF®405M 等蓝色荧光染料的偶联物检测低丰度目标,因为蓝色染料的荧光较低,并且比其他染料颜色可以产生更高的非特异性背景。
库存状态:由于 Biotium 提供大量抗体和偶联选择,因此可以订购一抗偶联物。CF® 染料和生物素偶联物的典型交货时间最长为 1 周,荧光蛋白和酶偶联物的交货时间最长为 2-3 周。
一抗偶联物的目录编号键
| Antibody # prefix | Conjugation | Ex/Em (nm) | Laser line | Detection channel | Dye Features |
|---|---|---|---|---|---|
| BNC04 | CF®405S | 404/431 | 405 | DAPI (microscopy), AF405 | CF®405S Features |
| BNC88 | CF®488A | 490/515 | 488 | GFP, FITC | CF®488A Features |
| BNC68 | CF®568 | 562/583 | 532, 561 | RFP, TRITC | CF®568 Features |
| BNC94 | CF®594 | 593/614 | 561 | Texas Red® | CF®594 Features |
| BNC40 | CF®640R | 642/662 | 633-640 | Cy®5 | CF®640R Features |
| BNC47 | CF®647 | 650/665 | 633-640 | Cy®5 | CF®647 Features |
| BNCB | Biotin | N/A | N/A | N/A | |
| BNUB | Purified | N/A | N/A | N/A | |
| BNUM | Purified, BSA-free | N/A | N/A | N/A |
Alexa Fluor、Pacific Blue、Pacific Orange 和 Texas Red 是 Thermo Fisher Scientific 的商标或注册商标;Cy 是 Cytiva 的注册商标;IRDye、LI-COR 和 Odyssey 是 LI-COR Bioscience 的注册商标。